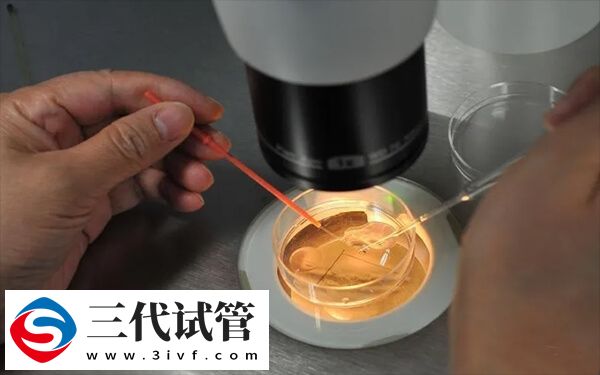
取卵22颗为什么不能鲜移(图1) 取卵22颗为什么不能鲜移(图1)

试管取卵22颗的患者,可能会对身体造成一定的伤害,比如卵巢过度刺激、腹水、腹痛或是出血等,这通常不利于鲜胚移植的,毕竟鲜胚移植对于患者身体状态有条件,需要保持良好的身体状态、内膜环境及激素水平,而取卵数量多的患者一般达不到鲜胚移植要求,如果盲目移植,反而会引起身体不适,以及降低移植成功率。
取卵22颗不能移植鲜胚的原因
试管移植胚胎一般分为鲜胚、冻胚、囊胚这三种,其中,移植鲜胚的条件尤为苛刻,需要患者在取卵后,卵巢没有损伤,内膜厚度达标,其次就是没有腹水,所以当患者做试管取卵后,若是取卵数量在22颗以上,那么一般是不建议当月移植鲜胚的,这主要是因为以下几种原因:
1、易诱发腹水
做试管取卵数量在22个的患者,由于雌激素水平较高,所以很容易引发腹水等并发症,所以建议这类情况的患者,应该调理一段时间以后才能进行移植,比如在第二个月移植冻胚,以降低对身体的负面影响。
2、影响着床
如果女性取卵20个以上以后,可能会给身体带来比较严重的损伤,甚至会使卵巢刺激过度,如果这时盲目的进行鲜胚移植,可能会影响到胚胎的正常着床,毕竟卵巢过度刺激可能带来严重的并发症,比如腹痛、出血,严重还可能引起休克。
3、降低成功率
取卵数量大于20个不仅诱发腹水,还影响着床,自然在一定程度上影响移植的成功率,尤其是移植鲜胚的患者,毕竟鲜胚发育不是特别完善,如果患者身体状态较差,那么就会使移植的成功率还会非常低。





